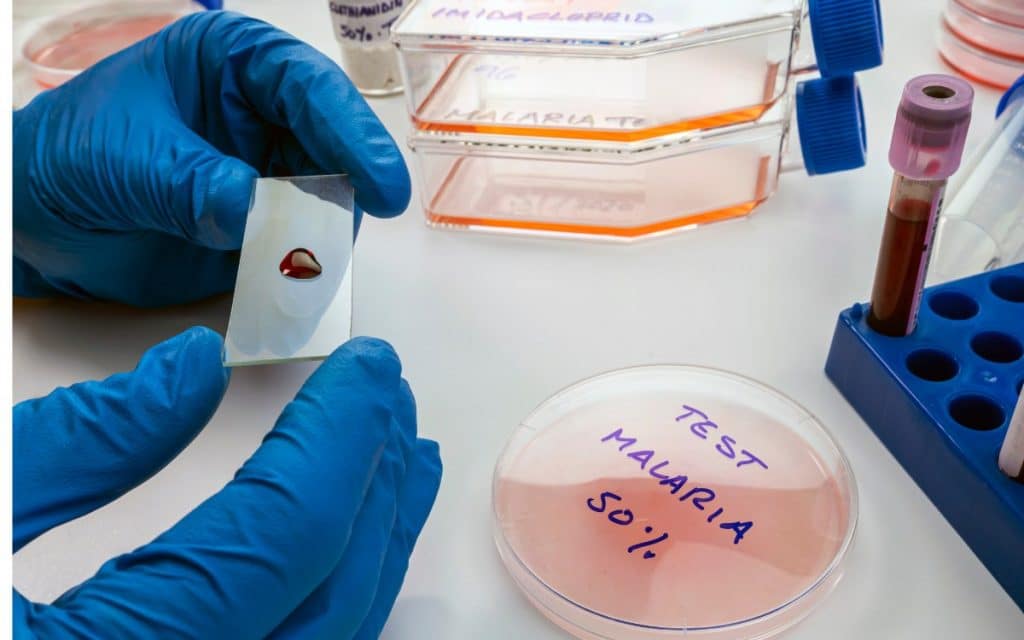

ICT Malaria
Innovative ICT Solutions: RevolutionizingRevolutionizing the Fight Against Malaria
When struggling with malaria, a lethal sickness affecting millions internationally, Information and Communication Technology (ICT) is becoming an increasingly important tool. Leveraging technology, revolutionary solutions empower researchers, healthcare companies, and groups with the assets they need to salary extra effective warfare on this pervasive fitness menace.

The Power of Predictive Modelling
Predictive modeling, an ahead-searching, statistics-driven procedure, exploits ICT’s electricity to forecast future tendencies based on beyond and modern records. It’s an effective technique that lets malaria prevention firms anticipate malaria outbreaks. With sufficiently advanced notes, they can take strategic and focused measures to intrude before explosions become good-sized. The advanced geographic data gadget (GIS) era helps those fashions, helping pinpoint hotspots and expertise in the spatial distribution of malaria.
Read More:
Digital Disease Surveillance and Monitoring
ICT additionally aids in ailment surveillance and monitoring, supplying actual-time updates on disease development. Digital tools, cellular programs, and net-based structures accumulate and consolidate data from numerous resources. This information provides a holistic angle at the epidemiology of malaria in precise areas. The aggregated records let fitness authorities tune ailment spread, display developments, follow management measures quickly, and examine the effectiveness of their interventions.

UtilizingUtilizing Mobile Health Technologies
Mobile health technology, frequently called mHealth, is reshaping malaria prevention and remedy. Today, mobile apps are available to help both healthcare experts and the overall public. Those tools offer healthcare carriers access to up-to-date research, diagnostic aids, and treatment pointers. For the wider public, they provide valuable facts on preventative measures, signs, and treatment alternatives.
Virtual Learning and Training Platforms
With the advent of ICT, digital mastering structures have become increasingly common. These platforms ensure that healthcare workers, specifically in far-flung or aid-bad settings, can get admission to ultra-modern malaria studies, receive training on new remedy protocols, and network with other specialists globally. Regularly updating information and abilities ensures their preparedness to address malaria in their local groups.
Undeniably, the modern use of ICT in beating malaria is revolutionizing the sector. These tools and systems improve malaria prevention and management efforts, fostering a proactive and assertive method in combating this deadly scourge.
Understanding the Role of ICT in Malaria Prevention and Control
Before we recognize the considerable impact Information and Communication Technology (ICT) has on the war in opposition to malaria, it is essential to understand its foundational position in prevention and management measures. Today, ICT is more than a series of gadgets; it is a crucial part of fitness interventions globally.
Enhancing Communication and Outreach
One of the essential thing roles of ICT in preventing malaria entails improving communication and outreach. Before ICT appeared, disseminating information about preventive measures and treatment options for malaria became an arduous venture. Now, through systems with websites, social media, and cell programs, facts can instantly be added to a huge-ranging target audience. Effectively, this allows the wider attain of attention campaigns and fitness education programs, contributing significantly to malaria prevention.

Data Collection, Storage, and Analysis
ICT has also revolutionized how fitness-associated statistics are accrued, stored, and analyzed. Today, medical examiners use numerous ICT tools, digital surveys, and cellular applications to collect statistics of malaria instances and transmit them in real time to databases. With these records at their fingertips, the health government can map out malaria hotspots, pick out crucial developments, and make knowledgeable choices on how to direct their assets. This method is pivotal in the effective control and eventual eradication of malaria.
Improving Diagnosis and Treatment
ICT also can make contributions drastically to the diagnosis and remedy of malaria. For instance, telemedicine technologies permit medical experts in remote areas to talk with specialists in actual time, facilitating the correct analysis and timely treatment of malaria instances. Additionally, e-learning platforms provide crucial training to those health workers, equipping them with the skills they need to fight this debilitating ailment.
Pioneering Innovation
Finally, ICT is a platform for innovation in combatting opposition to malaria. From predictive modeling that could assume outbreaks to virtual reality technology for training medical experts, ICT keeps to gas current improvements that might result in malaria eradication.
In essence, the role of ICT in malaria prevention and management is enormous, encompassing numerous regions from communique and outreach to statistics collection and evaluation and from improving analysis and treatment systems to pioneering sparkling, modern solutions. In tandem with clinical research and on-the-floor interventions, ICT holds the electricity to convert the panorama of malaria prevention and control, paving the direction of malaria-unfastened communities.
Powerful Tools at Our Fingertips: How ICT is Transforming Malaria Research
As a bold combatant in the war towards malaria, ICT, or Information and Communications Technology, is converting the game. It’s no secret that malaria is a disease that has plagued humanity for hundreds of years. Yet, in our technologically advanced world, we’ve powerful gear at our fingertips, which can be moving the dynamics of malaria studies, pushing boundaries, and constantly paving the manner towards a malaria-loose global.
Which gear, you ask?
Big Data and Artificial Intelligence
Big Data is a colossal set of complicated statistics, and with ICT, researchers can now analyze and understand this information like never before. AI algorithms can kind via these records and hit upon styles that provide helpful insights into malaria transmission, chance factors, populace behavior, and more. This functionality considerably enhances researchers’ potential to make accurate predictions and create strategic and tailored interventions that target the areas of highest want. Furthermore, AI-powered predictive fashions are an incredibly effective device, frequently automating the time-ingesting and burdensome obligations related to traditional studies techniques.

Geographical Information Systems (GIS)
GIS is another powerful device reworking the sector of malaria research. By mapping and visualizing geographic facts, GIS enables researchers to apprehend the spatial relationships and patterns associated with malaria. It offers insights into variables together with variations in weather, migration styles, and environmental changes, all of which play critical roles in the distribution and prevalence of malaria. With GIS, researchers can use intervention techniques more efficiently and efficaciously, resulting in a higher likelihood of achievement in removing the disorder in unique regions.
Sensor-Based Technology
Sensor-based technology, such as Internet of Things (IoT) device monitors and remote sensing equipment, may be utilized to monitor the disorder vectors and host environments. These technologies offer non-stop, correct, and value-powerful statistics, enabling researchers to monitor and manipulate for factors that power malaria transmission. This is beneficial in far-off or aid-restricted settings where consistent, on-the-ground surveillance might not be possible or dependable.

In the end, whether AI and Big Data, GIS generation, or the state-of-the-art sensor era, ICT is undoubtedly making its presence felt in the combat against malaria. Equipped with powerful equipment at our fingertips, we are more prepared than ever to chase down and eliminate this persistent health danger. The possibilities for ICT and malaria studies are expanding each day, and with it, our hopes for a malaria-loose destiny.







